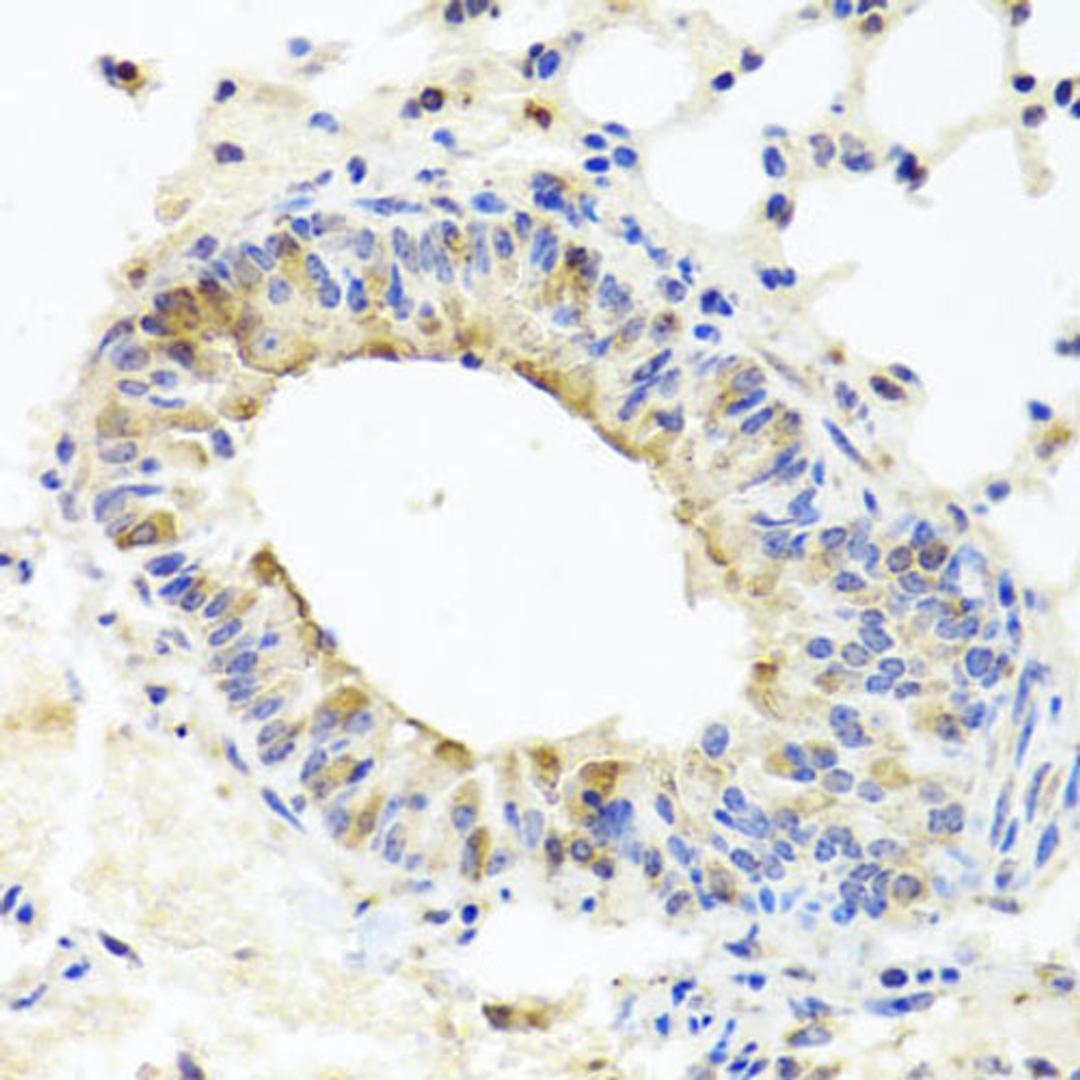
Immunohistochemistry - MUC16 antibody (A10005)
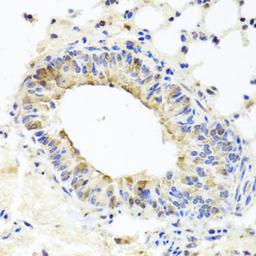
Immunohistochemistry - MUC16 antibody (A10005)

MUC16 Rabbit pAb
Product Details
- Cat. No.
- A10005
- Type
- Primary Antibody
- Clonality
- Polyclonal
- Host
- Rabbit

The supplier does not provide quotations for this antibody through SelectScience. You can search for similar antibodies in our Antibody Directory.
Description
This gene encodes a protein that is a member of the mucin family. Mucins are high molecular weight, O-glycosylated proteins that play an important role in forming a protective mucous barrier, and are found on the apical surfaces of the epithelia. The encoded protein is a membrane-tethered mucin that contains an extracellular domain at its amino terminus, a large tandem repeat domain, and a transmembrane domain with a short cytoplasmic domain. The amino terminus is highly glycosylated, while the repeat region contains 156 amino acid repeats unit that are rich in serines, threonines, and prolines. Interspersed within the repeats are Sea urchin sperm protein Enterokinase and Agrin (SEA) modules, leucine-rich repeats and ankyrin (ANK) repeats. These regions together form the ectodomain, and there is a potential cleavage site found near an SEA module close to the transmembrane domain. This protein is thought to play a role in forming a barrier, protecting epithelial cells from pathogens. Products of this gene have been used as a marker for different cancers, with higher expression levels associated with poorer outcomes.
Biological Information
- Clonality: Polyclonal
- Host: Rabbit
- Reactivity: Human, Mouse, Rat